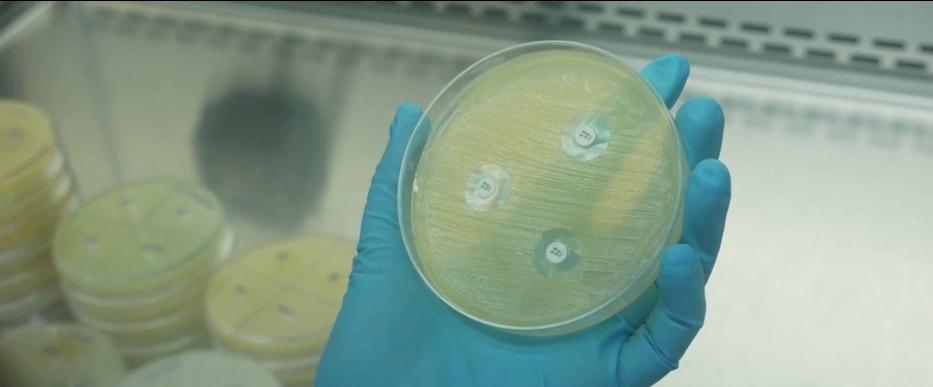

O alerta faz parte de uma investigação mais ampla sobre contaminação pela bactéria em alimentos prontos, que já causou internações e algumas mortes (Reprodução TV)
O Departamento de Agricultura emitiu um alerta de saúde pública para duas refeições prontas da marca HelloFresh que podem conter a bactéria Listeria monocytogenes: Cheesy Pulled Pork Pepper Pasta e Unstuffed Peppers with Ground Turkey. A contaminação está ligada ao espinafre fornecido pelas empresas Sno Pac Foods e Del Mar Foods.
As refeições foram enviadas diretamente aos consumidores via programa de assinaturas da companhia e não são comercializadas em supermercados. A orientação é de não consumo, descarte ou devolução ao fornecedor dos produtos contaminados, bem como a higienização de superfícies que tenham entrado em contato com os alimentos.
A agência ressalta que mais produtos podem ser adicionados à lista de recall à medida que a investigação avança. Nas últimas semanas alguns produtos do fabricante vendidos em lojas como o Walmart testaram positivo para a cepa de listeria, que foi associada a 20 doenças, incluindo quatro mortes, em 15 estados até 25 de setembro. Este surto envolveu massas alimentícias contaminadas em refeições prontas para consumo.
A bactéria pode causar doenças graves, especialmente em idosos, gestantes, recém-nascidos e pessoas com sistema imunológico debilitado. Os sintomas são dores musculares, febre, diarreia, dores de cabeça, rigidez no pescoço, confusão, perda de equilíbrio e convulsões. Para mais informações, os clientes podem contatar a FreshRealm pelo telefone 1-888-244-1562 ou e-mail customerservice@freshrealm.com.
